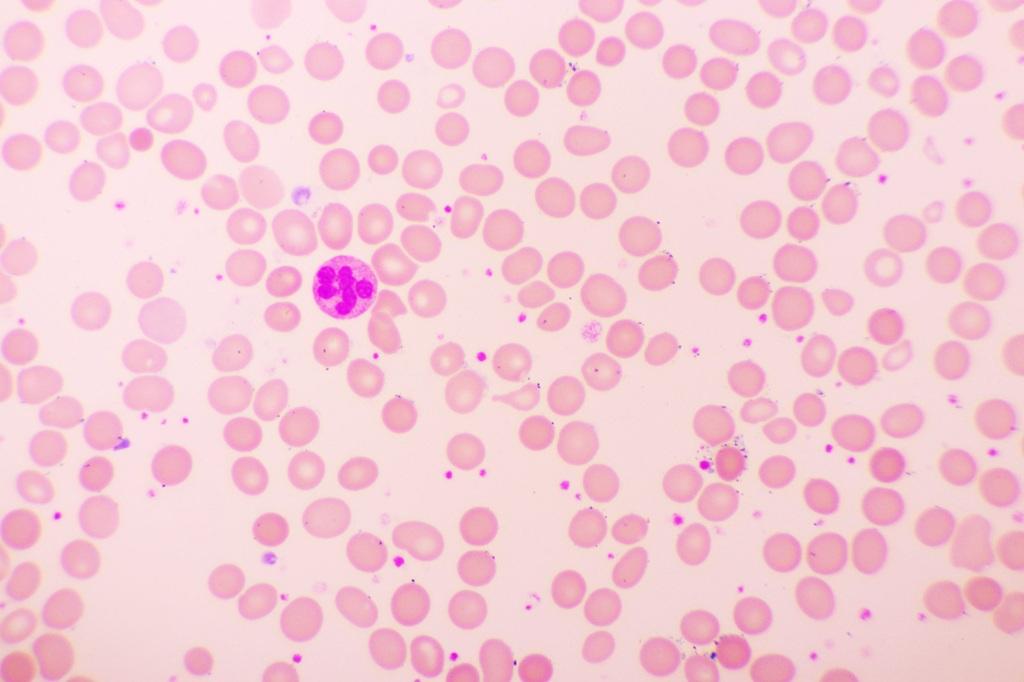

کبودی یا اکیموز زمانی ایجاد میشود که رگهای خونی کوچک زیر پوست پاره شده و خون به بافتهای زیرین نفوذ کند، که باعث تغییر رنگ پوست و ایجاد کبودی میشود. اگرچه اکثر افراد گاهی به دلیل ضربه دچار کبودی میشوند و این وضعیت معمولاً نگرانکننده نیست، کبودی های مکرر، بدون دلیل مشخص یا همراه با خونریزی در جای دیگر بدن میتواند نشان دهنده بیماری های زمینهای یا مشکلات انعقادی باشد. در این مقاله از سلام دنیا، به علت کبودی بدن چیست، چه بیماری هایی باعث کبودی بدن میشوند؛ اختلالات خونی مرتبط، تشخیص، درمان، پیشگیری و زمان مناسب مراجعه به پزشک میپردازیم.
چه عواملی باعث کبودی میشوند؟
وقتی به بدن ضربه وارد میشود، سیستم انعقادی خون معمولاً جلوی خونریزی را با تشکیل لخته میگیرد و از ایجاد کبودی جلوگیری میکند. اگر خون به درستی لخته نشود، احتمال کبودی افزایش مییابد.
عوامل اصلی کبودی عبارتند از:
- سن: پوست افراد مسن نازکتر و شکنندهتر میشود و لایه چربی محافظ اطراف رگها کاهش مییابد که باعث افزایش حساسیت به کبودی میشود.
- داروها: داروهایی مانند رقیقکنندههای خون (وارفارین، کلوپیدوگرل، ریواروکسابان، آپیکسابان)، داروهای ضد التهاب غیر استروئیدی (آسپرین، ایبوپروفن، ناپروکسن، سلکوکسیب) و استروئیدها میتوانند توانایی خون در لخته شدن را کاهش دهند. همچنین برخی مکملها و گیاهان دارویی مانند روغن ماهی، سیر و جینکو بیلوبا ممکن است این اثر را تشدید کنند.
- بیماری های پزشکی: بیماریهای خونی مانند هموفیلی A و B، بیماری فون ویلبراند، کاهش تعداد پلاکتها (ترومبوسیتوپنی) ناشی از شیمیدرمانی، لوکمیا، سیروز کبدی، کمخونی آپلاستیک، سندروم کوشینگ، سندروم اهلرز-دانلوس و کمبود ویتامینهای مهم مانند ویتامین C و K از عوامل مهم کبودی هستند.
- عوامل دیگر: قرارگیری طولانی مدت در معرض آفتاب (پورپورای اکتینیک)، سوءتغذیه، بیماریهای مزمن کلیوی و کبدی، دیابت، لوپوس، سیگار کشیدن و برخی بیماریهای ارثی و خودایمنی نیز میتوانند باعث کبودی شوند.
حتما بخوانید: درمان خانگی کبودی بدن
اختلالات / بیماری خون چیست؟
اختلالات خون شرایطی هستند که یک یا چند جزء خون را تحت تأثیر قرار میدهند. این اختلالات با تغییر حجم، ساختار یا عملکرد این اجزا، روند طبیعی بدن را مختل میکنند. اختلالات مختلفی از خون وجود دارد که معمولاً بر اساس جزئی از خون که تحت تأثیر قرار میگیرد، طبقهبندی میشوند.
نمونههایی از اختلالات پلاکتی عبارتند از:
- هموفیلی
- بیماری فون ویلبراند
- ترومبوسیتوپنی یا کاهش تعداد پلاکت
- ترومبوسیتوز یا افزایش تعداد پلاکت
نمونههایی از اختلالات گلبول سفید عبارتند از:
- لنفومها
- لوکمیاها
- میلومها
- لکاپنی یا کاهش تعداد گلبول سفید
- لوکوستوز یا افزایش تعداد گلبول سفید
نمونههایی از اختلالات خون که عمدتاً گلبولهای قرمز را تحت تأثیر قرار میدهند:
- کمخونیها
- اسفروسیتوز ارثی
- تالاسمی
- اریتروپنی یا کاهش تعداد گلبول قرمز
- اریتروسیتوز یا افزایش تعداد گلبول قرمز
حتما بخوانید: علت کبودی بدن چیست
کدام بیماری های خونی باعث کبودی میشوند؟
کبودی زمانی رخ میدهد که رگهای خونی کوچک در حالی که پوست سالم است، پاره شده و خون به بافتهای اطراف نفوذ میکند. این وضعیت به نام کوفتگی یا کنتوزیون نیز شناخته میشود. با تماس هموگلوبین خون با اکسیژن خارج از رگ، رنگ آن تغییر میکند و رنگهای قهوهای، بنفش و قرمز کبودی را ایجاد میکند. در روند بهبود معمول، بدن از خون برای انتقال پلاکتها، گلبولهای سفید و سایر عوامل انعقادی به محل آسیب دیده استفاده میکند. این مواد روند ترمیم و بستن رگهای آسیبدیده را شروع میکنند. برخی اختلالات خونی میتوانند اجزای خون لازم برای بهبود را تحت تأثیر قرار دهند. این وضعیت ممکن است باعث خونریزی طولانی زیر پوست شود، کبودیها بهراحتی ایجاد شده، مناطق وسیعی را پوشش داده و بهخوبی بهبود نیابند.

بیماری های خونی معمول مرتبط با کبودی غیرطبیعی عبارتند از:
- هموفیلی: بیماری ژنتیکی که باعث کمبود عامل انعقادی هشتم (هموفیلی A) یا نهم (هموفیلی B) میشود.
- بیماری فون ویلبراند: نقص در پروتئین فون ویلبراند که برای انعقاد خون ضروری است.
- کمبودهای نادر عوامل انعقادی: کمبود عوامل انعقادی غیر از موارد هموفیلی A و B.
- اختلالات عملکرد پلاکت: بیماریهایی که عملکرد پلاکتها را مختل میکنند، مانند سندرم برنارد-سولیه، سندرم پلاکت خاکستری و ترومباسیتوپنی گلانتزمن.
- لوکمیاها: سرطانهایی که از مغز استخوان شروع میشوند و میتوانند تولید پلاکت یا عوامل انعقادی را مختل کنند.
حتما بخوانید: درمان و رفع کبودی زیر چشم
- ترومبوسیتوپنی: کاهش تعداد پلاکتها به دلیل هر علت زمینهای.
- سندروم کوشینگ: افزایش غیرطبیعی هورمون کورتیزول در بدن است که میتواند باعث پوست شکننده و کبودی آسان شود.
- سندروم اهلرز-دانلوس (EDS): گروهی از بیماریهای ارثی که بافت همبند، پوست، دیواره رگها و مفاصل را تحت تأثیر قرار میدهد. به دلیل شکنندگی این بافتها کبودی آسان رخ میدهد.
- کمبود ویتامینها: کمبود ویتامینهایی که در انعقاد خون نقش دارند مانند ویتامین K و C نیز میتواند باعث کبودی آسان شود. سوءتغذیه احتمال کمبود این ویتامینها را افزایش میدهد. پزشک میتواند با انجام آزمایش خون کمبود ویتامینها را تشخیص داده و مکمل تجویز کند.
نحوه تشخیص علت کبودی
اگرچه کبودی گاهبهگاه معمولاً جای نگرانی ندارد، کبودی آسان ممکن است علامت بیماری باشد. در صورت مشاهده کبودیهای مکرر، مهم است با پزشک مشورت کنید تا علت آن مشخص شود. علاوه بر معاینه جسمی، پزشک سوالاتی درباره سابقه پزشکی خانوادگی شما خواهد پرسید و احتمالاً آزمایش خون برای اندازهگیری تعداد پلاکتها و زمان لخته شدن خون درخواست میکند.

علت کبودی در کودکان
کودکان به دلیل فعالیت زیاد، ورزش و حرکتهای سریع معمولاً بیشتر از بزرگسالان کبود میشوند. اما اگر کودک شما بیشتر از حد معمول کبود میشود، ممکن است علت آن دارو یا بیماری زمینهای باشد. در صورت مشاهده کبودیهای مکرر و بدون علت در کودک همراه با علائم زیر، با پزشک کودک تماس بگیرید:
- بثورات پوستی
- بزرگ شدن شکم
- تب
- تعریق یا لرز
- درد استخوان
- ناهنجاریهای صورت
حتما بخوانید: علت سیانوز [کبودی] نوزاد و کودکان چیست
درمان کبودی
اکثر کبودیها بدون درمان خاصی در چند روز تا دو هفته بهبود مییابند. روشهای کمککننده شامل:
- استفاده از کمپرس سرد با پوشش محافظ روی پوست به مدت 15 تا 20 دقیقه
- بالا نگه داشتن عضو آسیبدیده برای کاهش تورم
- مصرف مسکنهای بدون نسخه مانند استامینوفن (تایلنول) برای کاهش درد
نحوه پیشگیری از کبودی
برای کاهش احتمال کبودی میتوان اقدامات زیر را انجام داد:
- مشورت با پزشک درباره داروهای مصرفی و هرگز قطع یا تغییر خودسرانه داروها
- رعایت تغذیه مناسب با مصرف ویتامینهای C و K یا مکملهای تجویز شده
- دقت در هنگام راه رفتن، حذف موانع در محیط زندگی
- استفاده از نرده هنگام بالا و پایین رفتن از پله
- انجام تمرینات تعادلی برای بهبود هماهنگی و تعادل
- استفاده از تجهیزات محافظتی هنگام ورزش
چه زمانی باید برای کبودی به پزشک مراجعه کرد؟
در شرایط زیر باید فوراً به پزشک مراجعه کنید:
- کبودیهای شدید، گسترده یا دردناک
- کبودی بدون علت مشخص یا پس از ضربههای بسیار جزئی
- کبودی همراه با خونریزی از سایر نقاط بدن
- کبودی مکرر و افزایش ناگهانی تعداد آنها
- همراهی کبودی با علائم دیگری مانند خونریزی بینی، خستگی، سرگیجه
- شک به خشونت خانگی یا سوءاستفاده که ممکن است با کبودیهای غیرمعمول همراه باشد
حتما بخوانید: تفاوت کبودی و هماتوم
کمبود کدام ویتامین باعث کبودی بدن میشود
چندین کمبود تغذیهای میتوانند باعث کبودی شوند، از جمله:
- ویتامین K
- ویتامینهای گروه B
- ویتامین E
- ویتامین D
- روی (زینک)
- مس

سخن آخر
کبودی ناشی از پارگی مویرگهای خونی و نفوذ خون به بافت زیر پوست است. این وضعیت معمولاً طبیعی و بیخطر است اما کبودیهای مکرر، بزرگ یا بدون علت مشخص ممکن است نشاندهنده بیماریهای خون، اختلالات انعقادی یا اثرات جانبی داروها باشد. تشخیص دقیق و مدیریت مناسب توسط پزشک اهمیت زیادی دارد. همچنین رعایت نکات پیشگیری و پیروی از توصیههای پزشکی به کاهش احتمال کبودی کمک میکند. در صورت نگرانی از کبودیهای مکرر یا شدید حتماً با پزشک خود مشورت کنید و بدون راهنمایی دارویی داروها را قطع نکنید.
مطالب مرتبط:
علائم هشدار دهنده کمبود ویتامین C
نکاتی برای کاهش کبودی و تورم بعد از جراحی زیبایی بینی

دیدگاه ها